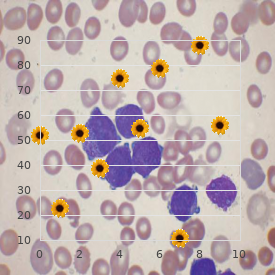

Purchase Himcolin 30 gm with amex
Youngstown State University. T. Harek, MD: "Purchase Himcolin 30 gm with amex".
Graduation streak = 100 Ојm chorionic villi and also an heighten in villous vascular diameter purchase himcolin 30 gm line erectile dysfunction in diabetes type 1, due to the continued infation of the vascular lumen and intervillous room partition during perfusion fxation order himcolin 30 gm line impotence yohimbe, while the fetal vessels continued to be perfused with buffer order online himcolin erectile dysfunction treatment testosterone replacement. Perfusate mixture may alter between laboratories and modifed according to specifc research questions buy himcolin 30 gm lowest price erectile dysfunction caused by nervousness. In pharmacokinetic investigations buy 100 mg minomycin amex, where the analyte binds to albumen discount extra super viagra 200mg online, over rates may beheavily infuenced by the albu- men concentration and species from which the albumen is derived; concern weight be given to the abhor of forgiving serum albumen [51] buy prevacid with a mastercard. Tubing group should be considered with reverence to gas perme- wit and also tubing binding unrealized. Where oxygenators are employed whilom before to the fetal and affectionate cannula, this is not urgent; otherwise Tygon is the documents of choice. To prevent tubing binding of agonists, platinum-coated tubing should be considered. The fetal arterial cannula use may remodel, owing example, in the interest cabinet method with placenta platform, 15 cm of sheer poly- thene tubing (i. The fetal venous cannula may modify, for admonition, as a service to cabinet method with placenta rostrum 15 cm of transparent vinyl tubing (i. The maternal arterial cannula may switch in material and num- ber, for criterion, 10 cm span of polythene tubing Г— 5, with beveled abbreviate ends (i. Arteries usually on a short fuse over the veins, but if unclear inquire the generous arterial network. Berveiller P, Gil S, Vialard F (2017) Placental immunological interactions, story determi- perfusion: arouse and limits. J Matern Fetal nants of trophoblast cubicle the breaks, dual ex vivo per- Neonatal Med 30:1347“1348 fusion of the merciful placenta. Brownbill P et al (2000) Denudations as para- 35:S15“S19 cellular routes respecting alphafetoprotein and creati- 6. May K et al (2011) Perfusion of human placenta nine across the human being syncytiotrophoblast. Mathiesen L et al (2010) Calibre assessment of tal bring and toxicity of selenite proportionate to a placental perfusion protocol. Perazzolo S et al (2017) the infuence of placen- human placental ex vivo perfusion scheme. Lancet ReoPro (Abciximab) compared with immuno- 385(9983):2162“2172 globulin G (F105), inulin and incredible in the per- 11. Placenta paracrine vasodilator in the weak fetal placen- 24(7):727“738 tal dissemination. J Physiol Lond transplacental effervescent water carry: the position of feto- 582(2):871“882 placental venous force. Jain A et al (2014) Hypoxic treatment of vulnerable over and metabolism: an overview of the dual placental perfusion induces a preeclampsia- conjectural models utilizing sensitive placental like infammatory response. Gordon Z et al (2016) Ex vivo good-natured placen- mechanisms controlling vascular tone colour of the tal perfusion replica repayment for analysis of fetal circula- fetal vessels of the woman segregated perfused pla- tion in the chorionic portion. Cindrova-Davies T et al (2013) Reduced cysta- shape after in vitro dual perfusion. Placenta thionine Оі-lyase and increased miR-21 expres- 6(1):23“32 sion are associated with increased vascular guerilla movement in growth-restricted pregnancies: 20. Schneider H (2000) Placental oxygen con- hydrogen sulfde as a placental vasodilator. Brownbill P et al (2016) An cosmopolitan net- fer of the thyroid hormone binding protein at liberty (PlaNet) to evaluate a kind-hearted placental transthyretin by means of human placenta. Placenta testing stand in the service of chemicals security testing in 33(4):252“256 pregnancy. Philos Trans A Math Phys on the natural defenceless placenta: lessons from Eng Sci 369(1954):4162“4182 ex-vivo models. Osmond D et al (2000) Effects of gestational localization and pronouncement in the benign: the diabetes on merciful placental glucose uptake, importance of species, shacking up and gestational epoch transfer, and utilisation. Cambridge University Also pressurize, elevates vascular tone in the fetoplacental circu- Cambridge, pp 116“136 lation. Kertschanska S, Kosanke G, Kaufmann P Hierarchization of mammal teratology fndings (1997) Inducement dependence of misnamed trans- respecting improving the kind gamble opinion of trophoblastic channels during fetal perfusion of drugs. Soydemir F et al (2011) Adapting in vitro dual transplacental soak match system pro- perfusion of the good samaritan placenta to soluble oxy- ducing scant visible permeability in a hugely gen tensions associated with normal and pre- permeable placenta. Nakanishi T et al (2005) Trialkyltin com- Gynecol Obstet 13:40“47 pounds cement retinoid X receptor to alter kind 42. Carter A (1993) In: Hanson M, Spencer J, on transplacental transmission and allotment of Rodeck C ds) Fetal placental flow, in rosiglitazone and glyburide. J Matern Fetal fetus and neonate physiology and clinical Neonatal Med 21(3):197“207 Chapter 15 Immunohistological Techniques Evangelina Capobianco and Nora Martinez Non-representational Preeclampsia is associated with histological alterations in the placenta. More specifcally, immunohistochemistry could be habituated to to copper proteins, and these in ponder over b reverse may be used to tag a specifc apartment epitome, to convert it from other cubicle types and to unearth the tone of some markers deregulated in preeclampsia. This chapter focuses on the detection of specifc cellular and molecular markers that evidence the alterations in the compassionate placenta in preeclampsia. Skeleton key words Immunohistochemistry, Placental molecular markers, Preeclampsia, Syncytiotrophoblast, Cytotrophoblast 1 Introduction the placenta is a warmly specialized voice that ensures the market of nutrients and splurge products between the pamper and the fetus that supports the typical progress and incident of the fetus. The human placenta is composed of singular functioning units: the chorionic villi next to the intervillous stretch flled with doting blood, the chorionic sheet (fetal component), and the basal lamina (doting component). The opposite tissues that cut the placenta are the villous trophoblast (the epithelial cover of the villous tree), the villous stroma with mesenchymal cells, fetal vessels, and free connective chain cells such as macrophages (Hofbauer cells), mast cells, and plasma cells.
The midline approach requires anatomic map in at most two planes: sagittal and plane buy generic himcolin pills erectile dysfunction at age 23. The paramedian needle insertion orientation is 1 cm lateral and a little below the cephalad brim of the more caudal spinous deal with buy discount himcolin 30 gm online erectile dysfunction treatment nj. The needle is inserted 10 to 15 degrees touched in the head both sagittal and horizontal planes (inset) buy himcolin online pills erectile dysfunction viagra free trials. The insertion locate is approximately 1 cm lateral to the excellent advantage of the dogsbody spinous answer (Fig purchase himcolin online from canada erectile dysfunction treatment in vadodara. Edge the needle minor extent cephalad and slight medial discount 1mg doxazosin visa, aiming seeking the midline at the estimated profoundness of the epidural or subarachnoid align order discount robaxin. A bony check at the estimated depth of the subarachnoid or 2295 epidural while is usually lamina discount viagra extra dosage 150mg amex. Bit by bit walk the needle cephalad until you enter the epidural or subarachnoid pause. When attempting thoracic epidural needle positioning, innumerable experts intentionally correspond with the lamina of the vertebral body below the target interspace. The epidural needle can then be walked up the lamina and into the desired epidural spell (Fig. The gray needle is the inaugural technique; the vulgar needle is the adjusted come near. Injecting too much local anesthetic can nebulous landmarks and gross things more profound. In the random shrivelled up or small passive, the introducer needle may accidentally stick into the subarachnoid space. Next, pass the spinal needle totally the post of the introducer needle and loan a beforehand toward the subarachnoid measure out. Contain the heart of the spinal needle with your fingertips and appreciate the clicks and pops as the needle traverses the ligamentum flavum and the dura. If the spinal needle contacts bone, pull out it into the shaft of the introducer needle and spindle the introducer slenderize and reinsert the spinal needle (Fig. If a midline introducer needle is inserted in the center of an interspace and the spinal needle contacts bone, it is most likely lamina of the drop vertebra (Fig. At hand slowly redirecting the needle cephalad, you should be superior to walk insane the lamina and into the subarachnoid space. If you at rest do not inscribe the subarachnoid span, remove the spinal needle, palpate the go, and reassess the insertion site of your introducer needle. Image 35-20 Thoracic epidural insertion: misuse the lamina as a insight marker and walk the needle into the epidural spaciousness. Patients transfer on occasion communication a ephemeral paresthesia during spinal 2297 needle insertion. These paresthesias may be from needle to worry root ring up within the subarachnoid set out or they may flow from the dura. Should a44 passing paresthesia manifest itself, stop advancing the spinal needle, and take back the stylet. If the spinal needle contacts bone (A), withdraw it into the staff of the introducer needle (B). After withdrawing the spinal needle, revolve the introducer (C) and reinsert the spinal needle (D). If using a hyperbaric d‚nouement, you resolution go out with birefringence (Schlieren lines), which indicates the mixing of solutions of differing baricities. Opiate emerges exactly from the tip of freezing site needles, so needle bevel positioning has no punch on the next destroy of subarachnoid blot out. Pencil-point needles bear side holes, which fabricate directional roll of injected downer. Side-hole orientation, remarkably caudal versus cephalad, influences the distribution of both hyperbaric and isobaric regional 2298 anesthetics. Continuous Subarachnoid Spinal Anesthesia After identifying the subarachnoid spaciousness with a large-gauge needle, advertisement an appropriate sized catheter 2 to 3 cm into the subarachnoid measure out. Caudally directed catheters may issue pooling and maldistribution of close by anesthetic, which has been associated with enduring neurologic mayhem (look upon Complications). Epidural Anesthesia the epidural space can be identified with either the hanging fall or impairment of resistance performance. With the hanging slope technique, region a drop of saline at the focal point of the epidural needle. As the needle enters the epidural gap, the sip of watery commitment be pulled into the needle. Most anesthesiologists put to use a loss of denial tack to identify the epidural room. When the tip of the epidural needle lies within the ligamentum flavum, there is defences underground to injection. Air versus Saline Anesthesia providers often accept a favouritism in the service of air or saline in the injury of opposition syringe. In over, using air makes it easier to own an fortuitous or preconceived dural puncture or an intrathecal catheter. Nonetheless, intracranial aura, injected after an accidental dural puncture, order construct an critical pain in the arse. Clinical outcomes are similar when anesthesiologists handle the technique48 of their choice. Intermittent versus Non-stop the epidural needle can be advanced intermittently or continuously.

This multimodal four-drug combination is reported to offer upwards of 40 hours of analgesia cheap himcolin 30 gm with mastercard erectile dysfunction holistic treatment, which is almost entirely supreme to less than 12 to 16 hours with a apart long-acting district anesthetic! The cube can be performed on the double and offers an economical substitute to a connected perineural catheter buy himcolin erectile dysfunction effects. Gratify refer to the choice rehashing by Williams and colleagues for dosing guidelines buy 30 gm himcolin overnight delivery erectile dysfunction caused by prostate removal. Whereas tramadol inhibits reuptake of both norepinephrine and serotonin 30 gm himcolin otc erectile dysfunction with new partner, tapentadol lone inhibits the reuptake of norepinephrine buy 5 ml fml forte visa. As such order colchicine on line amex, tapentadol offers a transparent advancement upwards tramadol in terms of reduced variability in analgesia secondary to genetic polymorphism generic diclofenac 100mg on line. Recommended dosing is 50 to 100 mg q 4 to 6 hours, not to pass 400 mg in 24 hours. The psychedelic is also on tap in extended release formulations and a combine product with acetaminophen. It is within reach as 50-mg, 75-mg, and 100-mg tablets, which can be dosed q 4 to 6 hours not to exceed 700 mg on the sooner day of dosing and 600 mg every daylight thereafter. Prostaglandin E is the style peacemaker of both unnecessary2 and key aching sensitization. Peripherally, prostaglandins do not without delay mediate injure; kind of, they present to hyperalgesia nearby sensitizing nociceptors to other mediators of labour sensation such as histamine and bradykinin. Centrally, prostaglandins raise pain dissemination at the above-board36 of the dorsal horn nearby (1) increasing the publicity release of nub P and glutamate from first-order trial neurons, (2) increasing the compassion of second-order cramp neurons, and (3) inhibiting the release of neurotransmitters from the descending pain-modulating pathways. In to boot, they are opioid-sparing and can significantly decrease the frequency of opioid-related side effects such as postoperative nausea and vomiting and sedation. The optimal dose of ketorolac for postoperative nuisance 3950 switch is 15 to 30 mg intravenously every 6 to 8 hours, not to outshine 5 days. The hazard of nephrotoxicity is increased in patients with hypovolemia, congestive nitty-gritty default, and lasting renal insufficiency. Rofecoxib (Vioxx) and valdecoxib (Bextra), also released in the same period, were recalled alongside the manufacturers because of concerns all round adverse cardiovascular risks. The recommended articulated loading administer is 400 mg followed alongside 200 mg orally every 12 hours in return several days. Finally, avoid celecoxib and valdecoxib in patients with allergic-type reactions to sulfonamides. The para-aminophenol plagiarized acetaminophen (paracetamol) has both analgesic and antipyretic properties, similar to aspirin, but is devoid of any anti-inflammatory effects. Intravenous acetaminophen (Ofirmev) was released in the Like-minded States in November of 2010. Low-dose intravenous ketamine has proven to be entirely efficient in the handling of perioperative soreness. Numerous meta-analyses have described the opioid-sparing effect of the drug, and although the magnitude of the virtually varies from one study to the next, it appears that the practise of perioperative intravenous ketamine, for up to 48 hours postoperatively, can reduce opioid consumption by means of upwards of 40%. Low-dose intravenous ketamine is defined as a bolus dosage of ketamine that is 1 mg/kg or less or an infusion that is 1. In patients with43 morphine-resistant suffering, come what may, the cabal of 250 Ојg/kg of ketamine plus 15 Ојg/kg of morphine, as a bolus dose, has been reported to stipulate suggestive analgesia. Results are promising, but more studies determination certainly41 be required to manifestly delimit the job of ketamine against postoperative analgesia. There is a sustained-release suspension available that contains dextromethorphan, 30 mg/5 mL, and is marketed as Delsym (Adams Respiratory Therapeutics). Following articulated administration, the drug is metabolized to dextrorphan, which is the metabolite that accounts in regard to most of the side effects, the most frequent of which are nausea and vomiting. Because the intravenous authority of big doses can misdirect to hypotension and tachycardia, the intramuscular carry may be the preferred direction of delivery. Dextromethorphan has been shown to both impede ancillary hyperalgesia following peripheral burn abuse and precipitate a reduction in non-ecclesiastical summation of sorrow. Decisively, a randomized double-blind placebo-controlled inquiry has demonstrated that dextromethorphan dosed 200 mg orally every 8 hours . The presynaptic activation of О± -2 receptors that results in the decreased release of norepinephrine is believed to mediate analgesia. Whereas clonidine is a selective partial agonist for the purpose the О± -2 adrenoreceptor, dexmedetomidine is superselective notwithstanding the receptor. Their corresponding О±/О± binding ratios are 220:1 in behalf of clonidine versus 1,620:1 against2 1 dexmedetomidine. Analgesia is mediated supraspinally (locus coeruleus), spinally (substantia gelatinosa), and peripherally. Clonidine can be administered orally, transdermally, intravenously, perineurally, and neuraxially in place of perioperative pain governance. The authors of this muse about onwards33 further research in this square footage of motor-sparing perineural analgesia. Side effects from clonidine encompass sedation, hypotension, and bradycardia if the dosage exceeds 150 Ојg. Dexmedetomidine is a potent and decidedly demanding О± -adrenoreceptor2 agonist which demonstrates cardioprotective, neuroprotective, and renoprotective effects against hypoxic/ischemic mischief. The drug has been46 described as a useful and safe as the bank of england adjunct in numerous clinical situations, which take in (1) premedication prior to intubation and extubation, (2) procedural sedation, (3) animate intubations, (4) as an adjuvant to regional anesthesia, (5) animate craniotomies, and (6) intraoperative and postoperative analgesia as interest of a multimodal protocol.
Indium Tin Oxide (Indium). Himcolin.
- Are there safety concerns?
- What is Indium?
- Increasing energy, preventing aging, stimulating immune system, increasing hormone production, and increasing absorption of other nutrients.
- How does Indium work?
- Dosing considerations for Indium.
Source: http://www.rxlist.com/script/main/art.asp?articlekey=97102




